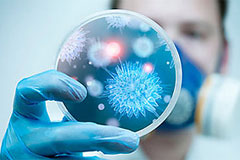
Изображение

Более 200 школ закрыты в Южной Корее из-за смертоносного вируса
-
Редакция
Более 200 школ закрыты в Южной Корее из-за смертоносного вируса
Власти Южной Кореи закрыли 209 школ из-за распространения в стране смертельно опасного коронавируса MERS, сообщают информагентства.
Читать новость на сайте...
Кто сейчас на конференции
Сейчас этот форум просматривают: нет зарегистрированных пользователей и 1 гость

